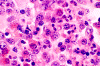
Com401-1-B5.gif (138860 bytes)

DiffQuick
DiffQuick
DiffQuick
DiffQuick
DiffQuick
| A 33 year-old Man with an
Epidural Mass in the Thoracic Spine. January, 2004, Case 401-1. Home Page |
A bone marrow biopsy was performed. The followings are representative photos taken from the bone marrow biopsy:
 |
 |
 |
 |
|
|
|
H. DiffQuick |
I. DiffQuick |
J. DiffQuick |
K. DiffQuick |
L. DiffQuick |